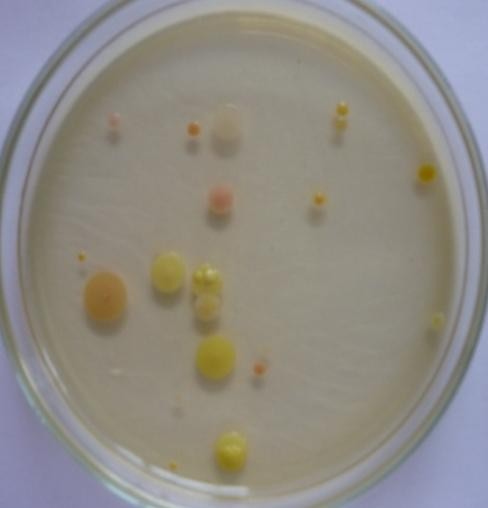
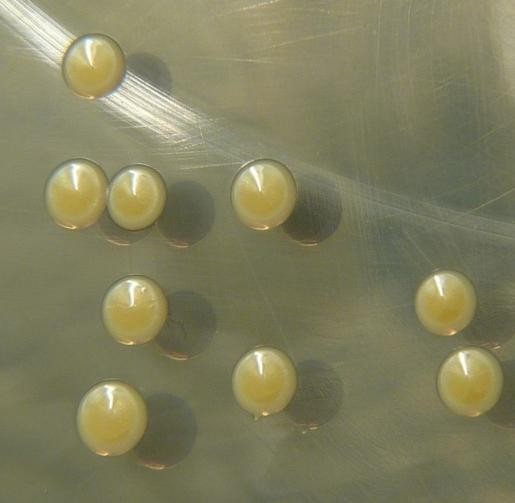
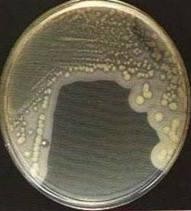
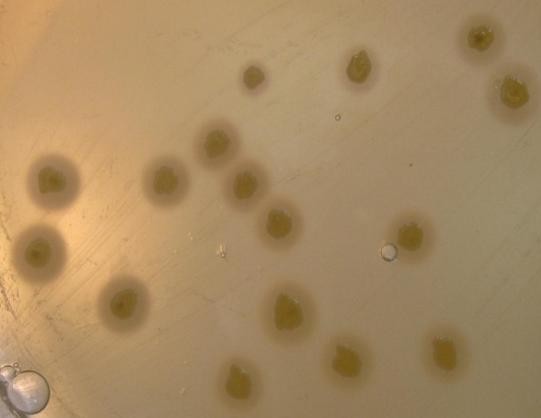
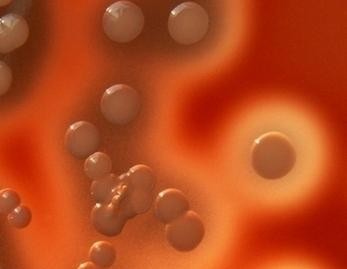
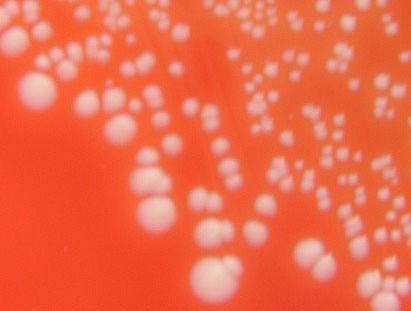

Материал: Литусов_Пиогенные кокки
Федеральное государственное бюджетное образовательное учреждение высшего образования
“Уральский государственный медицинский университет” Министерства здравоохранения Российской Федерации
Кафедра микробиологии, вирусологии и иммунологии
Литусов Н.В.
ЧАСТНАЯ БАКТЕРИОЛОГИЯ
(Пиогенные кокки)
Электронное иллюстрированное учебное издание
Екатеринбург 2017
Грамположительные аэробные кокки
Кокки представляют собой микроорганизмы шарообразной формы. Среди кокков имеются грамположительные и грамотрицательные, аэробные и анаэробные бактерии. Кокки имеют важное медицинское значение (таблица 1.1).
Таблица 1.1 – Основные представители кокков, имеющих медицинское
значение
Тип дыхания бактерий |
Грамположительные кокки |
Грамотрицательные кокки |
Аэробный |
стафилококки стрептококки энтерококки лейконостоки педиококки лактококки |
менингококки гонококки |
Анаэробный |
пептококки пептострептококки |
вейлонеллы |
Грамположительные аэробные кокки широко распространены в природе и объединяют патогенные, условно-патогенные и непатогенные микроорганизмы. С одной стороны, грамположительные аэробные кокки входят в состав нормальной микробиоты кожи и слизистых оболочек тела человека. С другой стороны, они способны вызывать у человека различные инфекционные заболевания. Основными представителями грамположительных аэробных кокков являются стафилококки, стрептококки, пневмококки и энтерококки.
Стафилококки
Впервые стафилококки были описаны в 1878 г. известным немецким микробиологом Р. Кохом (рисунок 1.1).

Рисунок 1.1 – Роберт Кох (Heinrich Hermann Robert Koch, 1843-1910 гг.).
Заимствовано из Интернет-ресурсов.
В чистой культуре стафилококки выделили французский микробиолог Л. Пастер из гноя фурункула человека и шотландский хирург А. Огстон из гноя абсцессов пациентов хирургического стационара (рисунок 1.2).


А Б
Рисунок 1.2 – А – Луи Пастер (Louis Pasteur, 1822-1895 гг.); Б – Александр Огстон (Alexander Ogston, 1844-1929 гг.). Заимствовано из Интернет-ресурсов.
В 1881 г. А. Огстон предложил родовое название - Staphylococcus. Подробное описание разных видов стафилококков представил в 1884 г. немецкий врач, профессор патологии и терапии О. Розенбах (рисунок 1.3).

Рисунок 1.3 – Оттомар Эрнст Феликс Розенбах (Ottomar Ernst Felix Rosenbach, 1851-1907 гг.). Заимствовано из Интернет-ресурсов.
Таксономическое положение и классификация стафилококков. Название стафилококков происходит от греческих слов “staphylоs” – виноград, гроздь и “coccos” – ягода, зерно.
Стафилококки относятся к типу Firmicutes, классу Bacilli, порядку Bacillales, семейству Staphylococcaceae, роду Staphylococcus. Этот род включает более 35 видов. Клинически значимыми для человека видами стафилококков являются S. aureus, S. epidermidis, S. saprophyticus, S. haemolyticus, S. intetrmedius и некоторые другие.
Среди стафилококков выделяют патогенные виды (в частности, S. aureus), условно-патогенные виды (например, S. epidermidis) и непатогенные виды (в частности, S. saprophyticus).
С точки зрения патогенетических признаков важной является классификация стафилококков по способности продуцировать плазмокоагулазу. По этому признаку стафилококки подразделяются на коагулазоположительные или коагулазопозитивные (к ним относится золотистый стафилококк – S. aureus) и коагулазоотрицательные или коагулазонегативные стафилококки (к ним относятся эпидермальный и сапрофитный стафилококки – S. epidermidis и S.
saprophyticus). Внутри вида по чувствительности к бактериофагам S. aureus
подразделяется на фагогруппы и фаговары.
Морфологические и тинкториальные свойства стафилококков. Стафилококки имеют шаровидную форму, диаметр клеток составляет 0,5-1,5 мкм. В мазках из культур, выросших на плотных питательных средах, они образуют скопления, напоминающие виноградные грозди. Такое расположение обусловлено делением клеток в разных плоскостях (рисунок 1.4).


Рисунок 1.4 – Схема образования виноградной грозди при делении стафилококков (красные линии показывают расположение плоскостей, в которых происходит
деление отдельных клеток).
В патологическом материале стафилококки располагаются небольшими группами (рисунок 1.5).


а б
Рисунок 1.5 – Стафилококки. Компьютерная визуализация (а) и сканирующая электронная микроскопия (б). Заимствовано из Интернет-ресурсов.
Стафилококки неподвижны, спор не образуют. Некоторые стафилококки могут образовывать микрокапсулу. По Граму стафилококки окрашиваются положительно (рисунок 1.6).


а б
Рисунок 1.6 – Стафилококки. Просвечивающая электронная микроскопия (а) и иммерсионная микроскопия, окраска по Граму (б). Заимствовано из Интернет- ресурсов.
Культуральные и биохимические свойства стафилококков. Стафилококки являются факультативными анаэробами, хорошо растут в аэробных условиях при температуре 35-40ОС на простых питательных средах (на мясо- пептонном агаре – МПА и в мясо-пептонном бульоне - МПБ) при рН 7,0-7,5. На МПА стафилококки образуют ровные круглые колонии S-формы диаметром 2-4 мм, которые могут быть окрашены в желтый, белый, оранжевый, кремовый цвета. Цвет колоний обусловлен наличием пигмента, синтезируемого стафилококками в аэробных условиях. Однако пигментообразование не является видовым признаком стафилококков. При размножении в жидких питательных средах стафилококки вызывают равномерное помутнение (рисунок 1.7).

а б в
Рисунок 1.7 – Колонии стафилококков на МПА (а), внешний вид колоний золотистого стафилококка на МПА (б, заимствовано из Интернет-ресурсов) и характер роста стафилококков в МПБ (в).
Стафилококки являются представителями галофильных (солеустойчивых) бактерий: они хорошо растут при содержании в питательной среде 10-15% хлорида натрия. Поэтому элективными для стафилококков являются питательные среды с повышенным содержанием NaCl: желточно-солевой агар (ЖСА), молочно- солевой агар (МСА), молочно-желточно-солевой агар (МЖСА). На желточно- солевом агаре патогенные стафилококки формируют колонии, окруженные радужным венчиком за счет разложения лецитина яичного желтка с помощью синтезируемого фермента лецитиназы (рисунок 1.8).

а б
Рисунок 1.8 – Характер роста стафилококков на желточно-солевом агаре (а) и зоны опалесценции вокруг колоний (б). Заимствовано из Интернет-ресурсов.
На кровяном агаре золотистый стафилококк формирует колонии, окруженные зоной гемолиза, эпидермальный стафилококк зон гемолиза не образует (рисунок 1.9).

а б
Рисунок 1.9 – Характер роста на кровяном агаре золотистого стафилококка (а) и эпидермального стафилококка (б). Заимствовано из Интернет-ресурсов.
Стафилококки обладают высокой биохимической активностью: они ферментируют в аэробных условиях многие углеводы до уксусной кислоты без газа. В частности, S. aureus разлагает до кислоты глюкозу, сахарозу, лактозу, маннит и не ферментирует мальтозу (рисунок 1.10).
Глюкоза Сахароза Лактоза Маннит Мальтоза
Рисунок 1.10 – Ферментация углеводов золотистым стафилококком.
Разные виды стафилококков ферментируют разный спектр углеводов. Дифференциально-диагностическое значение имеет тест на сбраживание глюкозы в анаэробных условиях. Ферментация глюкозы в анаэробных условиях с образованием молочной кислоты характерна для стафилококков и отличает их от стрептококков. Для проведения этого теста используют готовую среду с индикатором ВР (водорастворимым голубым) или среду Хью-Лейфсона с индикатором бромтимоловым синим. Исходная среда имеет лиловый (среда с индикатором ВР) или зеленый (среда Хью-Лейфсона) цвет. Аэробные бактерии окисляют глюкозу, то есть образуют кислоту только в среде без вазелинового масла (в аэробных условиях). Анаэробные бактерии ферментируют глюкозу, то есть образуют кислоту, только в среде с вазелиновым маслом (в анаэробных условиях). Факультативные анаэробы, к которым относится золотистый стафилококк, утилизируют глюкозу как в аэробных, так и в анаэробных условиях. Посев осуществляют уколом в столбик питательной среды в две пробирки. После посева для создания анаэробных условий среду в одной из пробирок заливают слоем
стерильного вазелинового масла. Культивирование проводят в течение 3-4 суток. Образование кислоты приводит к желтому окрашиванию столбика среды (рисунок 1.11).
1 2 3 4

а б
Рисунок 1.11 – Окисление глюкозы аэробными бактериями (а) и сбраживание глюкозы факультативными анаэробами (б). Пробирки 1 и 3 – с вазелиновым маслом (анаэробные условия), пробирки 2 и 4 – без вазелинового масла (аэробные условия).
Заимствовано и адаптировано из Интернет-ресурсов.
Стафилококки разжижают желатин в виде воронки, белки расщепляют до аммиака и сероводорода, не образуют индола.
Патогенные виды стафилококков (в частности, S. aureus) продуцируют плазмокоагулазу (коагулазоположительные) и фибринолизин. S. epidermidis и S. saprophyticus не продуцируют плазмокоагулазу (коагулазоотрицательные). Плазмокоагулазу и фибринолизин выявляют следующим образом. В пробирку с плазмой крови кролика вносят исследуемую культуру и инкубируют в течение суток при температуре 36ОС. При положительной реакции на плазмокоагулазу образуется плотный сгусток. Для выявления фибринолитической активности пробирку со сгустком оставляют в термостате еще на сутки. При наличии фибринолизина сгусток разжижается (рисунок 1.12). В последние годы в материале от больных со стафилококковой инфекцией все чаще обнаруживают коагулазоотрицательные стафилококки, считавшиеся ранее непатогенными бактериями.

Рисунок 1.12 – Свертывание плазмы крови коагулазой (верхняя пробирка) и разжижение сгустка фибринолизином (нижняя пробирка). Заимствовано из Интернет-ресурсов.
Стафилококки продуцируют каталазу (каталазоположительные), что отличает их от стрептококков и энтерококков, которые являются каталазоотрицательными бактериями. Каталаза разрушает перекись водорода, в
результате чего стафилококки защищены от высокотоксичных производных
кислорода. Продуцирование каталазы выявляется при добавлении к микробной культуре (на плотной питательной среде или на стекле) 1% раствора перекиси водорода. Положительная реакция проявляется выделением пузырьков газа (рисунок 1.13).


а б
Рисунок 1.13 – Выявление каталазы стафилококков с помощью перекиси водорода на питательном агаре (а) и на стекле (б). Заимствовано из Интернет-ресурсов.
Стафилококки являются оксидазоотрицательными, то есть не продуцируют оксидазу. Например, цитохромоксидазу выявляют путем нанесения капли суточной микробной культуры на фильтровальную бумажку, смоченную специальным реактивом (1% спиртовый раствор α-нафтола; 1% водный раствор N-диметил-β- фенилендиамина дигидрохлорида). В положительном случае на месте нанесения культуры появляется синее окрашивание. Для постановки этого теста выпускаются специальные слайды, пропитанные указанными реактивами (рисунок 1.14).


а б
Рисунок 1.14 – Тест на оксидазу с использованием индикаторных полосок (а) и слайдов (б). Синее окрашивание указывает на положительный результат.
Заимствовано из Интернет-ресурсов.
Стафилококки синтезируют каротиноидные пигменты, защищающие микробные клетки от оксидантов. Пигменты определяют цвет колоний стафилококков на МПА.
Синтез ДНКазы характерен для золотистого стафилококка. ДНКаза катализирует расщепление ДНК. Для ее выявления используют агар, содержащий водный раствор ДНК и раствор кальция хлорида. После выращивания культуры на чашку наносят раствор соляной кислоты. Положительная реакция проявляется прозрачной зоной деполимеризованной ДНК вокруг колоний на мутном фоне,
образующемся в результате взаимодействия ДНК с соляной кислотой (рисунок 1.15).

а б
Рисунок 1.15 – Выявление ДНКазы стафилококков: а – положительная реакция, б – отрицательная реакция. Стрелкой показана зона деполимеризованной ДНК.
Заимствовано из Интернет-ресурсов.
Сапрофитный и эпидермальный стафилококки продуцируют уреазу, которая расщепляет мочевину до аммония. Для определения уреазы культуру высевают в бульон с мочевиной. Изменение окраски среды на розовый свидетельствует о присутствии уреазы (рисунок 1.16).

Рисунок 1.16 – Тест на уреазу. Стрелкой показана положительная проба.
Заимствовано из Интернет-ресурсов.
В таблице 1.2 представлены дифференциальные признаки основных видов стафилококков, имеющих медицинское значение.
Таблица 1.2 – Дифференциальные признаки основных видов стафилококков
Признак |
S. aureus |
S. epidermidis |
S. saprophyticus |
Способность к росту в анаэробных условиях |
+ |
+ |
+/- |
Рост на среде с 10% натрия хлорида |
+ |
+/- |
+ |
Рост при: 15ОС 45ОС |
+ + |
- + |
+ +/- |
Ферментация углеводов до кислоты в аэробных условиях: - арабиноза |
- |
- |
- |